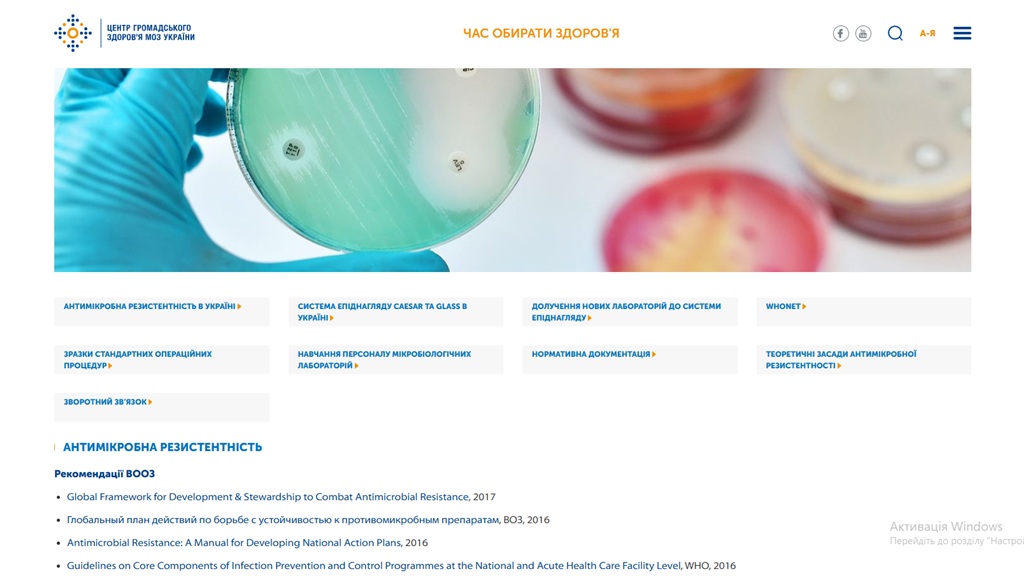

Хочете сайт, як у конкурента? Можна, але навіщо? Краще ми разом розробимо ваші дійсно унікальні сервіси.
Не знаєте, як ваші складні високопрофесійні послуги зробити простими і зрозумілими для клієнта? Пропоную вам свою комбіновану компетенцію практикуючого лікаря та веб-розробника.